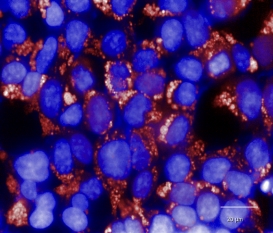

背外侧前额叶参与沉没成本效应的神经计算机制
正在做高内涵细胞成像/活细胞成像/细胞荧光成像?需要高质量的细胞成像微孔板?找不到符合要求的细胞成像板?
好消息!安捷伦细胞培养成像板限时促销,买的越多,越划算,助您完善细胞检测工作流程!
活动细则(仅限终端客户参与):
1. 一次性购买参加活动产品1-5箱,可享受目录价7.5折
2. 一次性购买参加活动产品6-10箱,可享受目录价7折
3. 一次性购买参加活动产品11箱及以上,可享受目录价6.5折
活动时间:2022年7月11日-2022年8月31日
☆ 安捷伦细胞培养成像板
安捷伦细胞培养成像板,采用透光性高的聚苯乙烯材质,底部超薄(黑色细胞板成像板),平整度高,带有底读检测功能,高分辨率成像,可广泛应用于In-Cell Western/高内涵成像/活细胞成像/细胞划痕实验及基于细胞培养的荧光实验!
96孔透明细胞培养成像微孔板
产品货号:204624-100
▪ 透明,底部透射,平底
▪ 表面TC处理
▪ 孔数量:96 孔
▪ 孔体积:400 μL
96孔黑色细胞培养成像微孔板
产品货号:204626-100
▪ 黑色,底部透射,平底
▪ 表面TC处理
▪ 孔数量:96 孔
▪ 孔体积:400 μL
384孔黑色细胞培养成像微孔板
产品货号:204628-100
▪ 黑色,底部透射,平底
▪ 表面TC处理
▪ 孔数量:384 孔
▪ 孔体积:140 μL
☆ 安捷伦细胞培养成像板应用效果
高内涵/激光共聚焦系统成像应用
Cytation C10 活细胞共聚焦成像分析系统成像效果
40X air-RFp GFp-2
(源于客户提供)
Opera™高通量高内涵筛选系统成像效果
60x water RFp hoechst
(源于客户提供)
3D细胞球高内涵成像应用
在安捷伦96孔黑色细胞培养成像板中接种已经培养好HT1080细胞球,通过DApI染料对胞核染色,并使用GFp与TRIC 联合标记细胞,在Cytation C10中进行3D细胞球Confocal高内涵成像(结果如下)。
Z-projection 高内涵成像结果
DApI+GFp+TRIC 20X Confocal
(源于客户提供)
3D重构成像结果
DApI+GFp 20X Confocal
(源于客户提供)
了解更多微孔板信息,
可直接扫码联系产品专员!
基因有限公司全国范围代理安捷伦的微孔板产品,提供适合您工作流程的高品质深孔板、储液加样槽、过滤微孔板以及细胞培养成像微孔板,所有微孔板符合ANSI标准尺寸。请在本文后留言或联系您身边的基因有限公司员工。
-
油菜遗传育种团队解析甘蓝型油菜红色系花色成因
2022-07-29 -
与衰老和特发性肺纤维化有关的蛋白质
2022-07-29 -
利用细菌清除湖泊中的塑料污染
2022-07-29 -
潘多拉的盒子?夏威夷熔岩洞穴中发现数千种未知细菌
2022-07-29 -
工程师开发出灵活且防水的石墨烯电路
2022-07-27 -
研究人员提出了一种新的快速表征和校准光谱仪的方法
2022-07-27 -
提高单细胞RNA测序的效率有助于揭示健康细胞和异常细胞之间的细微差异
2022-07-27 -
科学家发现了构成膀胱控制基础的传感器蛋白
2022-07-27 -
肠道菌群组成预测患者对他汀类药物的反应
2022-07-26 -
肺气肿严重程度与肺癌风险较高相关
2022-07-26